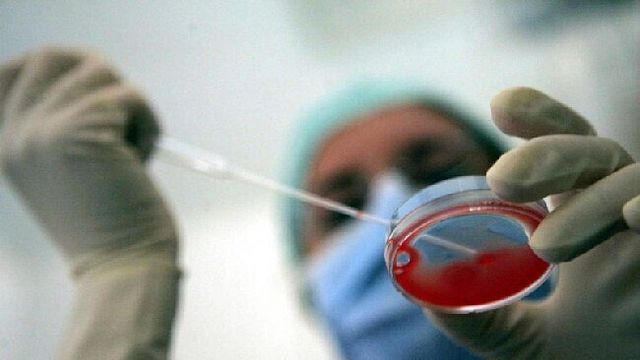

Un vaccino ancora in fase sperimentale a base di nanoparticelle, che nei test preclinici sui topi pare essersi dimostrato capace di prevenire il melanoma, il tumore del pancreas e il tumore della mammella triplo negativo, è stato sviluppato per fermare la diffusione dei tumori. Il risultato è pubblicato sulla rivista Cell Reports Medicine dai ricercatori dell'Università del Massachusetts Amherst: fino all'88% degli animali vaccinati non ha sviluppato la malattia; inoltre il vaccino ha anche ridotto, e in alcuni casi prevenuto completamente, la crescita della malattia.
La novità dello studio risiede nell'ingegnerizzazione delle nanoparticelle lipidiche che presentano dei peptidi (antigeni) specifici dei tumori, simili a delle etichette che avvisano le nostre cellule immunitarie di una minaccia (un po' come il vaccino antinfluenzale che contiene parti del virus inattivato). Per aumentare la potenza del vaccino, è stato aggiunto anche un "super adiuvante" che stimola ulteriormente il sistema immunitario a passare all'offensiva. Nel primo esperimento, i ricercatori hanno vaccinato un gruppo di topi con nanoparticelle contenenti peptidi del melanoma, prima di esporre gli animali a cellule di melanoma poche settimane dopo.
Dei topi vaccinati, l'80% è sopravvissuto ed è rimasto libero dal tumore per i 250 giorni di durata dello studio. Al contrario, tutti i topi che non sono stati vaccinati o che hanno ricevuto formulazioni diverse sono deceduti entro sette settimane. Nel secondo test, il team ha sostituito gli antigeni tumorali con un lisato composto da cellule tumorali frammentate. Anche in questo caso, il vaccino si è dimostrato efficace, fungendo da scudo nell'88% dei topi esposti a tumore del pancreas, nel 75% di quelli esposti al tumore della mammella triplo negativo e nel 69% di quelli esposti al melanoma. I risultati sono promettenti e i ricercatori intendono portare quanto prima il vaccino dal laboratorio alla pratica clinica.